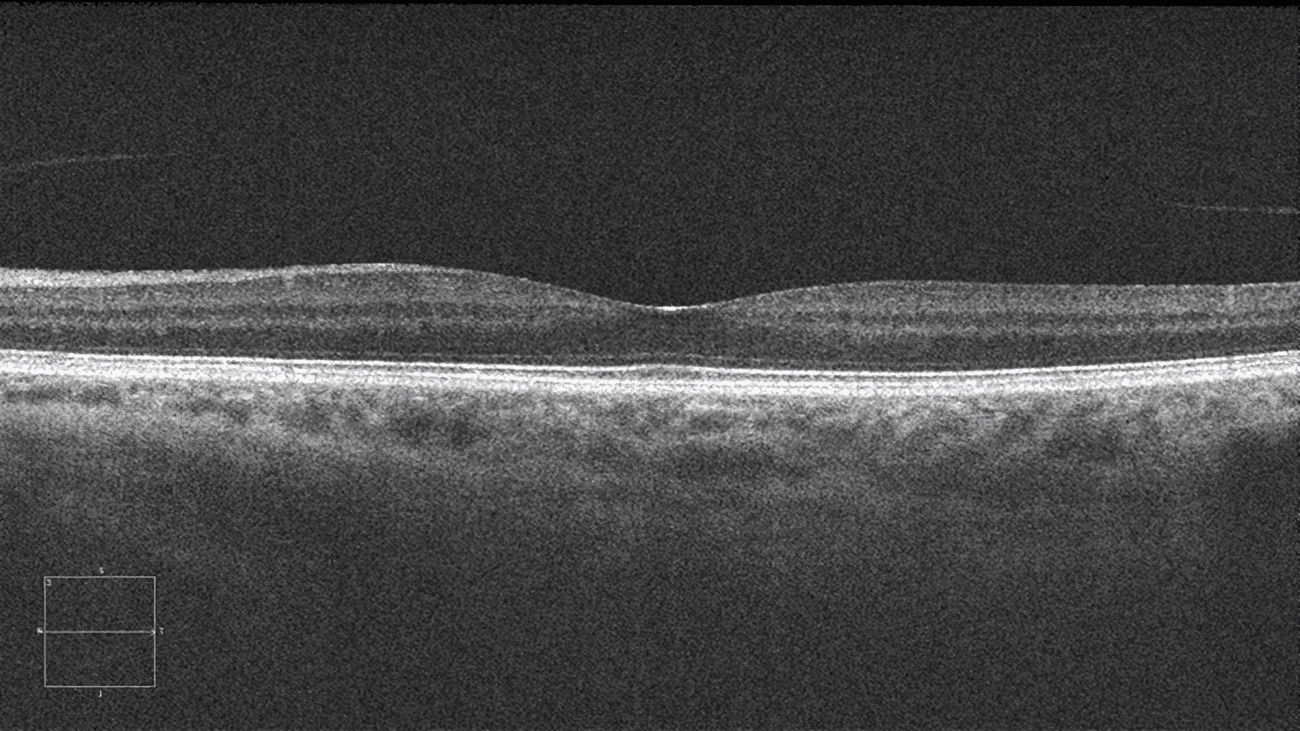
radiografia

Tecnologías de Análisis de Imagen Médica con inteligencia Artificial para el desarrollo de dispositivos médicos.
El objetivo de este proyecto de investigación es generar nuevo conocimiento sobre los modelos fundacionales, el aprendizaje auto supervisado y los modelos visión lenguaje en el campo de la imagen médica.
Esto servirá para agilizar los tiempos de desarrollo, validación y certificación de las soluciones de imagen médica basadas en IA, y, por lo tanto, supondrá una reducción del tiempo de llegada al mercado de estos productos, ofreciendo una ventaja competitiva para las empresas nacionales. Por lo tanto, la propuesta se presenta como una disrupción sobre la cadena de valor de los modelos de IA aplicados a imagen y texto médico.
Consorcio formado por las siguientes Empresas, Centros Tecnológicos y Universidades: Deusto SEIDOR, ULMA Medical Technologies, Erhardt Serikat, E Process Med, Cyber Surgery, Global Datamediatech Systems, Data Value Management, A3z Advanced Analytical Consulting Services, Centro Tecnológico Vicomtech, Universidad de Deusto e Instituto de Investigación Sanitaria BIOGIPUZKOA
Objetivos técnicos del proyecto
Avanzar en el conocimiento y en la implementación de modelos fundacionales en imagen médica a partir de bases de datos de la comunidad científica y propias del proyecto para estudios de imagen de radiología 2D y 3D e imágenes médicas no radiológicas. Existen múltiples modalidades distintas de imagen médica y no es evidente como procesar la información, si de manera conjunta o separada por modalidad, por órgano etc.
Investigar acerca de los distintos métodos de aprendizaje auto-supervisado que permitan optimizar el rendimiento de los modelos fundacionales. Aunque se ha empleado esta tecnología frecuentemente en visión por computador, su uso en imagen médica no está tan trabajado y los límites de la tecnología en este entorno no son muy conocidos, considerando las particularidades de la imagen médica.
Investigar distintos métodos para realizar de manera adecuada el fine-tuning de modelos fundacionales de imagen a tareas específicas (prediagnóstico de cáncer de próstata, diagnóstico de patologías respiratorias y enfermedades oftalmológicas) y en su explicabilidad para ofrecer una mayor confianza al clínico.
Investigar distintos métodos de generación sintética de imágenes médicas, incluyendo los más novedosos modelos de difusión y la inclusión de condicionamiento (por ejemplo, por texto) durante la generación. Avanzar en la definición y establecimiento de métricas apropiadas y específicas para evaluar la validez de las imágenes médicas sintéticas.
Ampliar el conocimiento en los modelos visión-lenguaje, capaces de procesar información médica multimodal (imagen+texto) para resolver gran variedad de tareas como la generación automática de reportes a partir de imagen